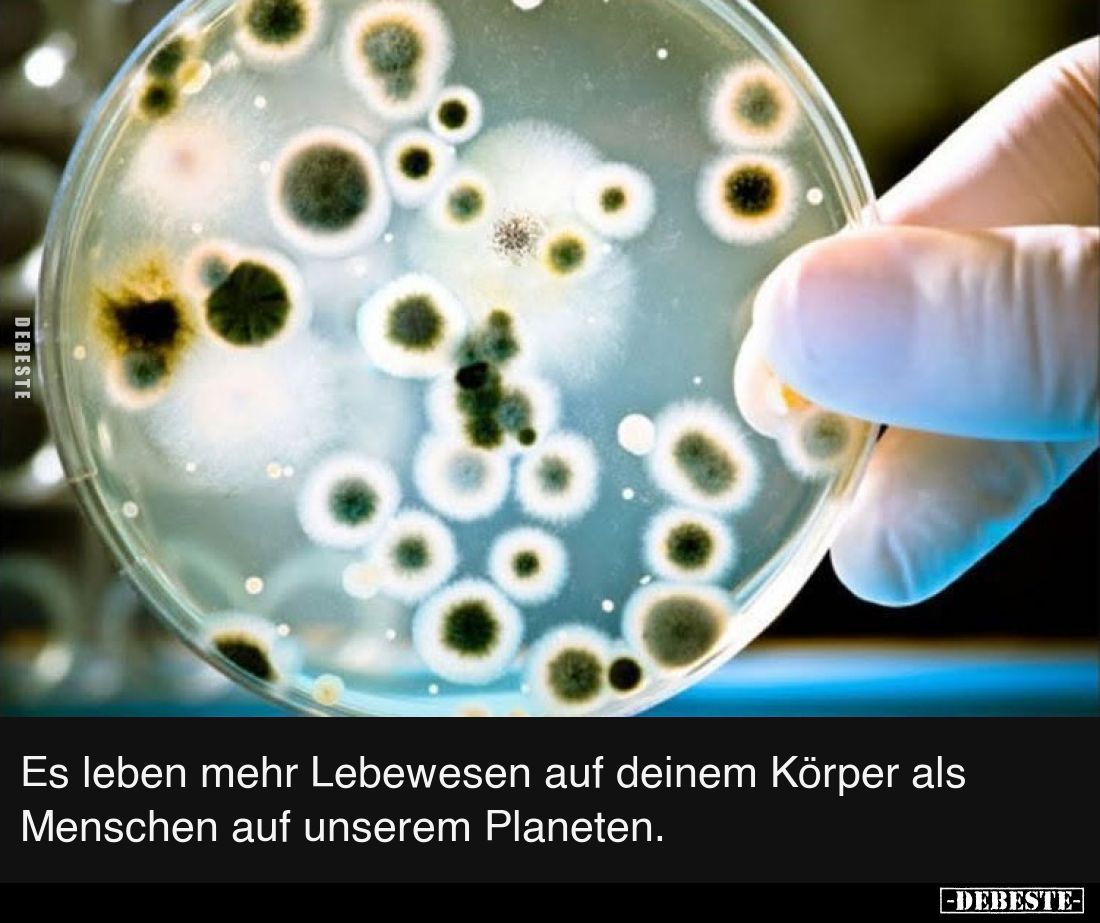
Es leben mehr Lebewesen auf deinem Körper als Menschen auf unserem Planeten.

Es leben mehr Lebewesen auf deinem Körper als Menschen..
» «
Kommentar (1)
tags: leben menschen
Es leben mehr Lebewesen auf deinem Körper als Menschen auf unserem Planeten.
Kommentare
Bitte melden Sie sich an, um einen Kommentar hinzuzufügen. Anmelden

WITZE


Gut Schwach (+28)